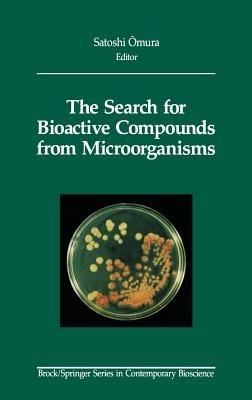
The Search for Bioactive Compounds from Microorganisms - cover

The Search for Bioactive Compounds from Microorganisms
Biologically active compounds isolated from microorganisms continue to be vital to the development of new drugs and agricultural chemicals. This book was prepared by current and past members of the laboratory of Dr. Satoshi Omura of the Kitasato Institute in Japan. Dr. Omura and his colleagues have discovered and studied a number of important antibiotics, and in their work they have pioneered new methods for screening microbes for interesting and important compounds. This book presents strategies and methods for identifying novel molecules with several types of biological activity. In addition, the book discusses the identification of microbial compounds of agrochemical importance, presents information on chemical screening methods, and concludes with chapters on microbial strain selection, fermentation technology, and genetic engineering of antibiotic-producing microorganisms. This book will be of great interest to scientists working in the very active and competitive fields of antibiotic and agrochemical discovery.
-
Curatore:
-
Editore:
-
Collana:Brock Springer Series in Contemporary Bioscience
-
Anno:1992
-
Rilegatura:Hardback
Le schede prodotto sono aggiornate in conformità al Regolamento UE 988/2023. Laddove ci fossero taluni dati non disponibili per ragioni indipendenti da Feltrinelli, vi informiamo che stiamo compiendo ogni ragionevole sforzo per inserirli. Vi invitiamo a controllare periodicamente il sito www.lafeltrinelli.it per eventuali novità e aggiornamenti.
Per le vendite di prodotti da terze parti, ciascun venditore si assume la piena e diretta responsabilità per la commercializzazione del prodotto e per la sua conformità al Regolamento UE 988/2023, nonché alle normative nazionali ed europee vigenti.
Per informazioni sulla sicurezza dei prodotti, contattare productsafety@feltrinelli.it